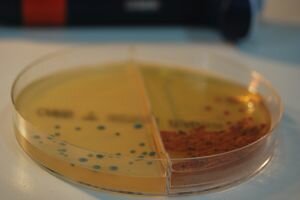
Controlar el intercambio de información genética es clave para frenar la diseminación intrahospitalaria de resistencias a antibióticos

-
 ESCUELA DE ENFERMERÍA CRUZ ROJA "FLORENCIA NIGHTINGALE"
ESCUELA DE ENFERMERÍA CRUZ ROJA "FLORENCIA NIGHTINGALE"
ALUMNA: Peralta Guevara Keren Sofia
Licenciatura en Enfermería 1° "C"
DOCENTE: Ing. Samara Machuca Figueroa
ASIGNATURA: Microbiología y Parasitología -
 Microscopio compuesto realizado por los hermanos Hans y Zacha- rias Janssen en 1590, en Midelburg, HOLANDA. (25 cm). Está for- mado por dos tubos de latón, soportando una lente cada uno, que se deslizan dentro de otro tubo de latón lo que permite el enfo- que.
Microscopio compuesto realizado por los hermanos Hans y Zacha- rias Janssen en 1590, en Midelburg, HOLANDA. (25 cm). Está for- mado por dos tubos de latón, soportando una lente cada uno, que se deslizan dentro de otro tubo de latón lo que permite el enfo- que. -
 Francesco Redi fue un médico, naturalista, fisiólogo, y literato italiano. Demostró que los insectos no nacen por generación espontánea,1 por lo que se le considera el fundador de la helmintología (el estudio de los gusanos).
Francesco Redi fue un médico, naturalista, fisiólogo, y literato italiano. Demostró que los insectos no nacen por generación espontánea,1 por lo que se le considera el fundador de la helmintología (el estudio de los gusanos). -
 Fue Anton van Leeuwenhoek, quien descubrió la vida microscópica.
Fue Anton van Leeuwenhoek, quien descubrió la vida microscópica.
Leeuwenhoek fue el primero en ver animales unicelulares, bacterias, glóbulos rojos y espermatozoides. -
 En 1775, Jenner empezó un minucioso estudio sobre la relación entre la viruela bovina y la de humanos. después de experimentar con animales descubrió que si tomaba un extracto de una llaga de viruela bovina y se la inyectaba a un ser humano, esa persona quedaba protegida contra la viruela.
En 1775, Jenner empezó un minucioso estudio sobre la relación entre la viruela bovina y la de humanos. después de experimentar con animales descubrió que si tomaba un extracto de una llaga de viruela bovina y se la inyectaba a un ser humano, esa persona quedaba protegida contra la viruela.
En 1798 publicó su investigación en 1798, en la que acuñó el término "vacuna", del latin "vacca" (vaca). -
 Miles Joseph Berkeley descubre un hongo (Phytophthora infestans) que produce la podredumbre de la patata.
Miles Joseph Berkeley descubre un hongo (Phytophthora infestans) que produce la podredumbre de la patata. -
Felipe Semmelweis propone la utilización de antisépticos para evitar la fiebre puerperal.
-
 Demostró que el cólera era producido por el consumo de aguas contaminados con partículas de material defecado en lugares donde el agua era consumida esta estaba contaminada por hueces en la ciudad de Londres
Demostró que el cólera era producido por el consumo de aguas contaminados con partículas de material defecado en lugares donde el agua era consumida esta estaba contaminada por hueces en la ciudad de Londres -
 A través de experimentos refutó definitivamente la teoría de la generación espontánea y desarrolló la teoría germinal de las enfermedades infecciosas. Por sus trabajos es considerado el pionero de la microbiología moderna, iniciando la llamada «Edad de Oro de la Microbiología».
A través de experimentos refutó definitivamente la teoría de la generación espontánea y desarrolló la teoría germinal de las enfermedades infecciosas. Por sus trabajos es considerado el pionero de la microbiología moderna, iniciando la llamada «Edad de Oro de la Microbiología». -
 Friedrich miescher comenzó sus investigaciones con los espermas de los salmones y descubrió la presencia de una serie de sustacias una acida y una fuertemente básica a la que denomino protamina y que se identifica con las histonas
Friedrich miescher comenzó sus investigaciones con los espermas de los salmones y descubrió la presencia de una serie de sustacias una acida y una fuertemente básica a la que denomino protamina y que se identifica con las histonas -
 Koch estudió con profundidad la transmisión directa del bacilo del carbunco (también llamado ántrax).
Koch estudió con profundidad la transmisión directa del bacilo del carbunco (también llamado ántrax). -
 Descubrió la importancia del vector biológico de la teoría metaxenica de la transmisión de enfermedades por agentes biológicos produciendo una fiebre amarilla por el mosquito
Descubrió la importancia del vector biológico de la teoría metaxenica de la transmisión de enfermedades por agentes biológicos produciendo una fiebre amarilla por el mosquito -
 El 24 de marzo de 1882, el Dr. Robert Koch anunció el descubrimiento del Mycobacterium tuberculosis, la bacteria que causa la tuberculosis. En esa época, la tuberculosis provocaba la muerte de una de cada siete personas en los Estados Unidos y Europa
El 24 de marzo de 1882, el Dr. Robert Koch anunció el descubrimiento del Mycobacterium tuberculosis, la bacteria que causa la tuberculosis. En esa época, la tuberculosis provocaba la muerte de una de cada siete personas en los Estados Unidos y Europa -
 Pasteur necesitaba hacer la comprobación de la eficacia de éstas en el ser humano. Es así como el 6 de Julio de 1885, hace más de cien años, Pasteur inocula la vacuna al joven José Meister, que había sido mordido 14 veces por un perro rabioso. Se conoce ya que la experiencia tuvo éxito.
Pasteur necesitaba hacer la comprobación de la eficacia de éstas en el ser humano. Es así como el 6 de Julio de 1885, hace más de cien años, Pasteur inocula la vacuna al joven José Meister, que había sido mordido 14 veces por un perro rabioso. Se conoce ya que la experiencia tuvo éxito. -
 Escherich es el descubridor de una bacteria que viven en el intestino estas bacterias no producen problemas pero algunos tipos pueden producir problemas y diarrea
Escherich es el descubridor de una bacteria que viven en el intestino estas bacterias no producen problemas pero algunos tipos pueden producir problemas y diarrea -
 Julius Richard Petri ejerció como médico militar y estuvo de ayudante de Robert Koch, siendo en 1887 cuando inventó la placa Petri que se utiliza en los laboratorios principalmente para el cultivo de microorganismos.
Julius Richard Petri ejerció como médico militar y estuvo de ayudante de Robert Koch, siendo en 1887 cuando inventó la placa Petri que se utiliza en los laboratorios principalmente para el cultivo de microorganismos. -
 Serguei Winogradski fue un destacado microbiológico descubridor del proceso biológico de la nitrificación la primera etapa del conocimiento de la quimioautotrofÍa
Serguei Winogradski fue un destacado microbiológico descubridor del proceso biológico de la nitrificación la primera etapa del conocimiento de la quimioautotrofÍa -
 El 3 de marzo de 1905, Schaudinn y el médico militar berlinés Erich Paul Hoffman, realizaron las primeras observaciones microscópicas del Treponema pallidum en la Clínica La Charité de Berlín, usando la coloración de Giemsa modificada ya que el Treponema era casi transparente
El 3 de marzo de 1905, Schaudinn y el médico militar berlinés Erich Paul Hoffman, realizaron las primeras observaciones microscópicas del Treponema pallidum en la Clínica La Charité de Berlín, usando la coloración de Giemsa modificada ya que el Treponema era casi transparente -
 Walter Reed confirma que la fiebre amarilla es transmitida por mosquitos, hecho previamente observado por Carlos Finlay en 1881.
Walter Reed confirma que la fiebre amarilla es transmitida por mosquitos, hecho previamente observado por Carlos Finlay en 1881. -
 Howard Taylor Ricketts demuestra que la fiebre de las Montañas Rocosas es transmitida por garrapatas, y aisló el microorganismo causante de la enfermedad (que él llamó rickettsia). Falleció por esa enfermedad.
Howard Taylor Ricketts demuestra que la fiebre de las Montañas Rocosas es transmitida por garrapatas, y aisló el microorganismo causante de la enfermedad (que él llamó rickettsia). Falleció por esa enfermedad. -
 David Hendricks Bergey fue un médico, micólogo, bacteriólogo estadounidense.
David Hendricks Bergey fue un médico, micólogo, bacteriólogo estadounidense. -
 El experimento de Griffith, llevado a cabo en 1928, fue uno de los primeros experimentos que demostró que las bacterias eran capaces de transferir información genética mediante un proceso llamado transformación.
El experimento de Griffith, llevado a cabo en 1928, fue uno de los primeros experimentos que demostró que las bacterias eran capaces de transferir información genética mediante un proceso llamado transformación. -
 Fleming hizo crecer el moho en un cultivo puro y descubrió que producía una sustancia que mataba a varias bacterias causantes de enfermedades. Identificó el moho como perteneciente al género Penicillium y, después de algunos meses de llamarlo "jugo de moho", el 7 de marzo de 1929 llamó a la sustancia penicilina
Fleming hizo crecer el moho en un cultivo puro y descubrió que producía una sustancia que mataba a varias bacterias causantes de enfermedades. Identificó el moho como perteneciente al género Penicillium y, después de algunos meses de llamarlo "jugo de moho", el 7 de marzo de 1929 llamó a la sustancia penicilina -
 Frits Zernike era un hombre matematico interesado por varias disciplinas científicas gano el premio nobel de física por su invento del microscopio
Frits Zernike era un hombre matematico interesado por varias disciplinas científicas gano el premio nobel de física por su invento del microscopio -
 Avery, MacLeod, y McCarty demostraron que el DNA procedente de una cepa virulenta lisa de neumococo pudo transformar una cepa rugosa en la variedad lisa. Éste es el primer experimento que concluye que el DNA es el material genético.
Avery, MacLeod, y McCarty demostraron que el DNA procedente de una cepa virulenta lisa de neumococo pudo transformar una cepa rugosa en la variedad lisa. Éste es el primer experimento que concluye que el DNA es el material genético. -
 Alfred Hershey y Martha Chase demuestran que el DNA era el material genético de algunos virus.
Alfred Hershey y Martha Chase demuestran que el DNA era el material genético de algunos virus. -
 A principios de la década de 1950, el biólogo estadounidense James Watson y el físico británico Francis Crick propusieron su famoso modelo de la doble hélice del ADN.
A principios de la década de 1950, el biólogo estadounidense James Watson y el físico británico Francis Crick propusieron su famoso modelo de la doble hélice del ADN.
El patrón de difracción tiene una forma de X representativa de la estructura helicoidal de doble cadena del ADN. -
 François Jacob y Jacques Monod proporcionan el primer ejemplo de control de la expresión de genes a nivel de transcripción: modelo del operón.
François Jacob y Jacques Monod proporcionan el primer ejemplo de control de la expresión de genes a nivel de transcripción: modelo del operón. -
 Marshall Nirenberg y Matthaei descubren que el codón UUU codificaba para el aminoácido fenilalanina, experimento que sentó las bases para la elucidación del código genético.
Marshall Nirenberg y Matthaei descubren que el codón UUU codificaba para el aminoácido fenilalanina, experimento que sentó las bases para la elucidación del código genético. -
 Woese y George E. Fox reconocen las archaeas como el tercer dominio de los seres vivos.
Woese y George E. Fox reconocen las archaeas como el tercer dominio de los seres vivos. -
 Frederick Sanger desarrolla el método de los dideoxinucleótidos para la secuenciación del DNA.
Frederick Sanger desarrolla el método de los dideoxinucleótidos para la secuenciación del DNA. -
 El físico alemán Ernest Ruska y el ingeniero en electricidad también alemán Max Knoll desarrollaron el primer microscopio electrónico de transmisión (MET) para la observación de materiales. La academia sueca en 1986 galardonó a Ernest Ruska con el premio Nobel por la invención de este microscopio.
El físico alemán Ernest Ruska y el ingeniero en electricidad también alemán Max Knoll desarrollaron el primer microscopio electrónico de transmisión (MET) para la observación de materiales. La academia sueca en 1986 galardonó a Ernest Ruska con el premio Nobel por la invención de este microscopio. -
 Desde 2003, una devastadora epidemia de gripe aviar causada por el virus altamente mortífero, el H5N1, ha afectado desde 2003, sobre todo a poblaciones de aves de corral de muchos países de Asia, Oriente Medio, Europa y África.
Desde 2003, una devastadora epidemia de gripe aviar causada por el virus altamente mortífero, el H5N1, ha afectado desde 2003, sobre todo a poblaciones de aves de corral de muchos países de Asia, Oriente Medio, Europa y África. -
 La enfermedad del legionario es una infección de los pulmones grave y muchas veces mortal (neumonía). Las personas generalmente la contraen al inhalar gotitas de agua que contienen bacterias
La enfermedad del legionario es una infección de los pulmones grave y muchas veces mortal (neumonía). Las personas generalmente la contraen al inhalar gotitas de agua que contienen bacterias -
 Hace poco más de 10 años, México sufrió una epidemia por una mutación del virus de la influenza. A finales de abril de 2009, el Gobierno, comandado entonces por Felipe Calderón, reconoció 20 muertos, la mayoría en Ciudad de México.
Hace poco más de 10 años, México sufrió una epidemia por una mutación del virus de la influenza. A finales de abril de 2009, el Gobierno, comandado entonces por Felipe Calderón, reconoció 20 muertos, la mayoría en Ciudad de México. -
 Y en octubre, una de las principales noticias científicas fue el inicio del primer ensayo en humanos de un tratamiento con células madre embrionarias.
Y en octubre, una de las principales noticias científicas fue el inicio del primer ensayo en humanos de un tratamiento con células madre embrionarias.
La compañía biofarmacéutica Geron Corporation, de California, intentará restaurar la sensibilidad y el movimiento de ciertos miembros en pacientes con lesiones graves de médula espinal. -
 Científicos de la Universidad de Minnesota (EE.UU.) desarrollaron una nueva tecnología de edición del genoma denominada TALENs, más barata y rápida, que permite a los científicos modificar genéticamente peces cebra, sapos, ganado y otros animales. Los investigadores pueden alterar o inactivar genes específicos con más habilidad, lo que también les permitirá aprender más sobre las enfermedades humanas.
Científicos de la Universidad de Minnesota (EE.UU.) desarrollaron una nueva tecnología de edición del genoma denominada TALENs, más barata y rápida, que permite a los científicos modificar genéticamente peces cebra, sapos, ganado y otros animales. Los investigadores pueden alterar o inactivar genes específicos con más habilidad, lo que también les permitirá aprender más sobre las enfermedades humanas. -
 Científicos japoneses de la Universidad de Kioto consiguieron fabricar en el laboratorio óvulos fértiles, con capacidad para ser fecundados, a partir de células madre de ratón. Los óvulos dieron lugar a una amplia descendencia de ratoncillos sanos. La investigación puede dar lugar a nuevos tratamientos para combatir la fertilidad femenina, especialmente en el caso de las mujeres que han agotado sus óvulos fértiles, por edad o por un tratamiento médico agresivo.
Científicos japoneses de la Universidad de Kioto consiguieron fabricar en el laboratorio óvulos fértiles, con capacidad para ser fecundados, a partir de células madre de ratón. Los óvulos dieron lugar a una amplia descendencia de ratoncillos sanos. La investigación puede dar lugar a nuevos tratamientos para combatir la fertilidad femenina, especialmente en el caso de las mujeres que han agotado sus óvulos fértiles, por edad o por un tratamiento médico agresivo. -
 El artículo, La historia temprana y la aparición de funciones moleculares y comportamiento de la red modular libre de escala, se publicó en Scientific Reports. Couatores, M. Aziz Fayez y Kelsey Caetano-Anollés, también de la Universidad de Illinois,
El artículo, La historia temprana y la aparición de funciones moleculares y comportamiento de la red modular libre de escala, se publicó en Scientific Reports. Couatores, M. Aziz Fayez y Kelsey Caetano-Anollés, también de la Universidad de Illinois, -
 17 de noviembre del 2017. La biología sintética permite a los científicos diseñar circuitos genéticos que se pueden colocar en las células, dándoles nuevas funciones como la producción de fármacos u otras moléculas útiles.
17 de noviembre del 2017. La biología sintética permite a los científicos diseñar circuitos genéticos que se pueden colocar en las células, dándoles nuevas funciones como la producción de fármacos u otras moléculas útiles. -
 En 2018, científicos de todo el mundo han logrado aplicar estas técnicas para monitorizar el desarrollo de embriones de vertebrados. En junio, un equipo, liderado por el experto en genética Jeffrey A. Farrell de la Universidad de Harvard (EE UU), describió los patrones de expresión génica de cada una de las células de un embrión de pez cebra.
En 2018, científicos de todo el mundo han logrado aplicar estas técnicas para monitorizar el desarrollo de embriones de vertebrados. En junio, un equipo, liderado por el experto en genética Jeffrey A. Farrell de la Universidad de Harvard (EE UU), describió los patrones de expresión génica de cada una de las células de un embrión de pez cebra. -
 El Director General de la Organización Mundial de la Salud (OMS), el doctor Tedros Adhanom Ghebreyesus, anunció el 11 de marzo de 2020 que la nueva enfermedad por el coronavirus 2019 (COVID-19) puede caracterizarse como una pandemia. La caracterización de pandemia significa que la epidemia se ha extendido por varios países, continentes o todo el mundo, y que afecta a un gran número de personas.
El Director General de la Organización Mundial de la Salud (OMS), el doctor Tedros Adhanom Ghebreyesus, anunció el 11 de marzo de 2020 que la nueva enfermedad por el coronavirus 2019 (COVID-19) puede caracterizarse como una pandemia. La caracterización de pandemia significa que la epidemia se ha extendido por varios países, continentes o todo el mundo, y que afecta a un gran número de personas. -
 Durante muchos años, la identificación de microorganismos ha dependido de la producción local de medios de cultivos para siembra y realización de pruebas bioquímicas, con la consiguiente menor estandarización de estas pruebas.
Durante muchos años, la identificación de microorganismos ha dependido de la producción local de medios de cultivos para siembra y realización de pruebas bioquímicas, con la consiguiente menor estandarización de estas pruebas.
Un avance el pre analítico es que se han desarrollado equipos que, de manera robotizada, logran sembrar muestras en formato líquido, sobre diversas placas para luego ser incubadas y analizadas. -
 Rusia fue el primer país del mundo en registrar una vacuna con el covid-19.
Rusia fue el primer país del mundo en registrar una vacuna con el covid-19.
De producción propia, la Sputnik V se aprobó en agosto y empezó a administrarse en diciembre en la capital, Moscú. FUENTE:https://www.bbc.com/mundo/noticias-55232518 -
 Un estudio genético ha detectado una adaptación a un virus respiratorio en personas cuyos ancestros provienen del este de Asia FUENTE:https://elpais.com/ciencia/2021-06-24/ya-hubo-una-epidemia-de-coronavirus-hace-25000-anos.html
Un estudio genético ha detectado una adaptación a un virus respiratorio en personas cuyos ancestros provienen del este de Asia FUENTE:https://elpais.com/ciencia/2021-06-24/ya-hubo-una-epidemia-de-coronavirus-hace-25000-anos.html -
 Investigadores del Consejo de Investigación Médica de Cambridge (Reino Unido) han creado, mediante ingeniería genética, una cepa sintética de E. coli en la que incluyeron varios aminoácidos no estándar. De esta manera, consiguieron que la bacteria sintética estuviera protegida de la infección viral. FUENTE:http://biotech-spain.com/es/articles/crean-una-bacteria-sint-tica-que-resiste-a-los-virus/
Investigadores del Consejo de Investigación Médica de Cambridge (Reino Unido) han creado, mediante ingeniería genética, una cepa sintética de E. coli en la que incluyeron varios aminoácidos no estándar. De esta manera, consiguieron que la bacteria sintética estuviera protegida de la infección viral. FUENTE:http://biotech-spain.com/es/articles/crean-una-bacteria-sint-tica-que-resiste-a-los-virus/ -
El nuevo trabajo del grupo de Álvaro San Millán, investigador del Consejo Superior de Investigaciones Científicas (CSIC) en el Centro Nacional de Biotecnología (CNB-CSIC), en colaboración con el Instituto Ramón y Cajal de Investigaciones Sanitarias (IRYCIS) y la Universidad de Oxford ha realizado la caracterización epidemiológica y genética de las bacterias intrahospitalarias que transmiten nuevas resistencias frente a antibióticos.
El nuevo trabajo del grupo de Álvaro San Millán, investigador del Consejo Superior de Investigaciones Científicas (CSIC) en el Centro Nacional de Biotecnología (CNB-CSIC), en colaboración con el Instituto Ramón y Cajal de Investigaciones Sanitarias (IRYCIS) y la Universidad de Oxford ha realizado la caracterización epidemiológica y genética de las bacterias intrahospitalarias que transmiten nuevas resistencias frente a antibióticos.
